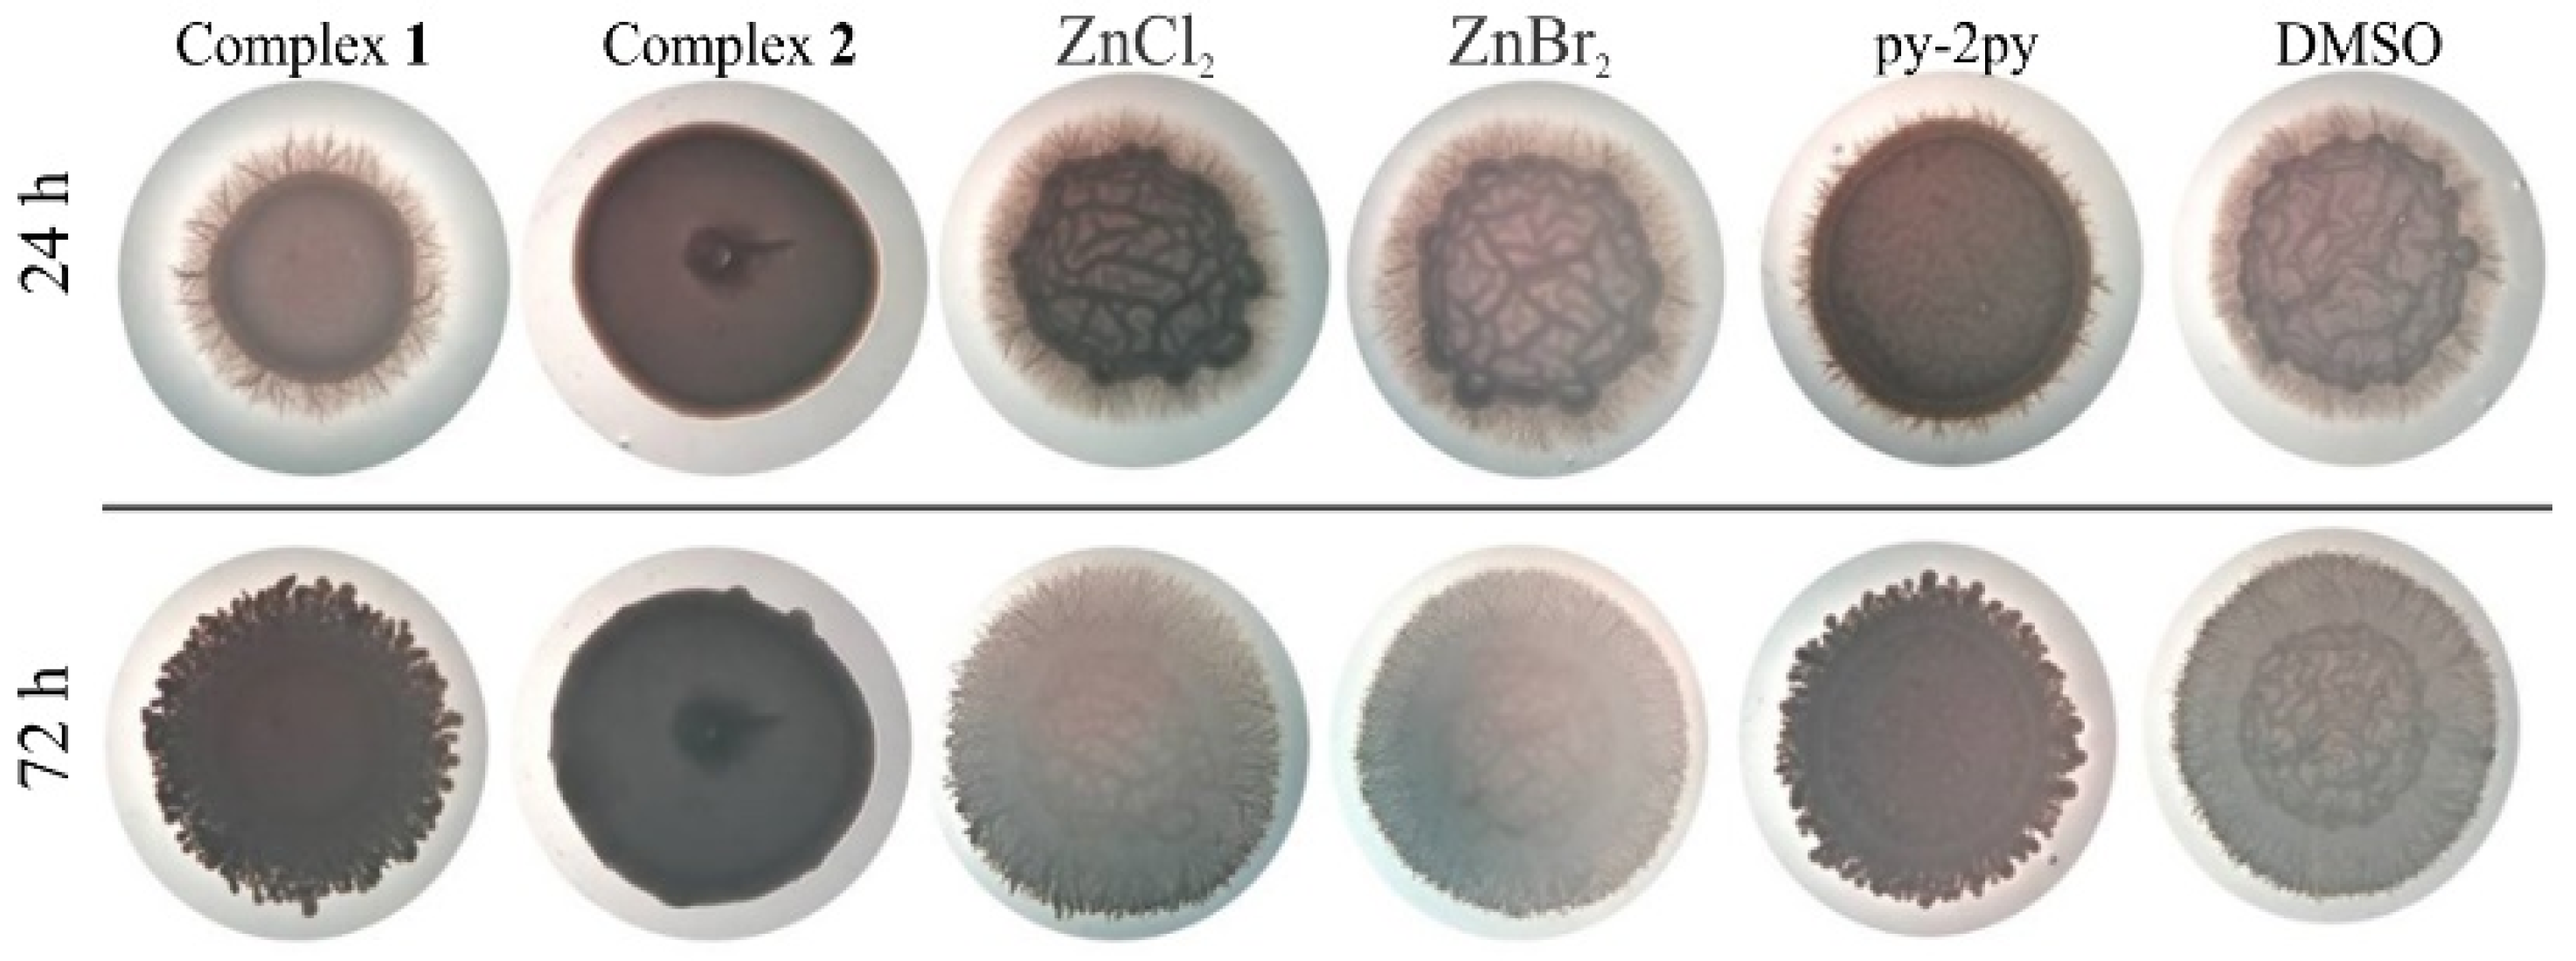

Zinc(II) Complexes with Dimethyl 2,2′-Bipyridine-4,5-dicarboxylate: Structure, Antimicrobial Activity and DNA/BSA Binding Study
Abstract
:1. Introduction
2. Results and Discussion
2.1. Synthesis and Structural Characterization of the Zinc(II) Complexes 1 and 2
2.1.1. Description of the Single Crystal Structures
2.1.2. Spectroscopic Characterization
2.2. Solution Stability of Complexes 1 and 2
2.3. Biological Activity Study
2.4. DNA Interaction
2.5. Protein Binding Study
2.5.1. Fluorescence Emission Spectroscopy
2.5.2. Synchronous Fluorescence Measurements
3. Materials and Methods
3.1. Materials and Measurements
3.2. Synthesis of Dimethyl 2,2′-Bipyridine-4,5-dicarboxylate
3.3. Synthesis of Zinc(II) Complexes 1 and 2
3.4. Crystallographic Data Collection and Refinement of the Structures
3.5. Antimicrobial Studies
3.5.1. Determination of Minimum Inhibitory Concentration (MIC) on Bacterial and Fungal Strains
3.5.2. Inhibition of Quorum Sensing Signaling Pathways, Testing Compounds Impact on the Production of Violacein and Prodigiosin Pigments
3.5.3. C. albicans ATCC 10231 Hyphae Formation
3.5.4. Inhibition of C. albicans ATCC 10231 Biofilm Formation
3.6. In Vitro Toxicity
3.7. Survival Assay on In Vivo Model Organism Caenorhabditis Elegans
3.8. DNA Interaction
3.9. Protein Binding Study
4. Conclusions
Supplementary Materials
Author Contributions
Funding
Data Availability Statement
Conflicts of Interest
References
- Osredkar, J.; Sustar, N. Copper and Zinc, Biological Role and Significance of Copper/Zinc Imbalance. J. Clin. Toxicol. 2011, S3, 495. [Google Scholar] [CrossRef] [Green Version]
- Krężel, A.; Maret, W. The biological inorganic chemistry of zinc ions. Arch. Biochem. Biophys. 2016, 611, 3–19. [Google Scholar] [CrossRef] [PubMed] [Green Version]
- Myari, A.; Malandrinos, G.; Deligiannakis, Y.; Plakatouras, J.C.; Hadjiliadis, N.; Nagy, Z.; Sòvágó, I. Interaction of Cu2+ with His–Val–His and of Zn2+ with His–Val–Gly–Asp, two peptides surrounding metal ions in Cu,Zn-superoxide dismutase enzyme. J. Inorg. Biochem. 2001, 85, 253–261. [Google Scholar] [CrossRef]
- Krishnamurthy, V.M.; Kaufman, G.K.; Urbach, A.R.; Gitlin, I.; Gudiksen, K.L.; Weibel, D.B.; Whitesides, G.M. Carbonic anhydrase as a model for biophysical and physical-organic studies of proteins and protein-ligand binding. Chem. Rev. 2008, 108, 946–1051. [Google Scholar] [CrossRef] [PubMed] [Green Version]
- Haase, H.; Rink, L. Multiple impacts of zinc on immune function. Metallomics 2014, 6, 1175–1180. [Google Scholar] [CrossRef]
- Kolenko, V.; Teper, E.; Kutikov, A.; Uzzo, R. Zinc and zinc transporters in prostate carcinogenesis. Nat. Rev. Urol. 2013, 10, 219–226. [Google Scholar] [CrossRef] [PubMed] [Green Version]
- Walkup, G.K.; Burdette, S.C.; Lippard, S.J.; Tsien, R.Y. A new cell-permeable fluorescent probe for Zn2+. J. Am. Chem. Soc. 2000, 122, 5644–5645. [Google Scholar] [CrossRef]
- Pellei, M.; Del Bello, F.; Porchia, M.; Santini, C. Zinc coordination complexes as anticancer agents. Coord. Chem. Rev. 2021, 445, 214088. [Google Scholar] [CrossRef]
- Michalczyk, K.; Cymbaluk-Płoska, A. The role of zinc and copper in gynecological malignancies. Nutrients 2020, 12, 3732. [Google Scholar] [CrossRef]
- Murakami, M.; Hirano, T. Intracellular zinc homeostasis and zinc signaling. Cancer Sci. 2008, 99, 1515–1522. [Google Scholar] [CrossRef]
- Li, Y.V. Zinc and insulin in pancreatic beta-cells. Endocrine 2014, 45, 178–189. [Google Scholar] [CrossRef] [PubMed]
- Taylor, C.G. Zinc, the pancreas, and diabetes: Insights from rodent studies and future directions. Biometals 2005, 18, 305–312. [Google Scholar] [CrossRef] [PubMed]
- Bjørklund, G.; Dadar, M.; Pivina, L.; Doşa, M.D.; Semenova, Y.; Aaseth, J. The role of zinc and copper in insulin resistance and diabetes mellitus. Curr. Med. Chem. 2020, 27, 6643–6657. [Google Scholar] [CrossRef] [PubMed]
- Szunyogová, E.; Mudroňová, D.; Györyová, K.; Nemcová, R.; Kovářová, J.; Piknová-Findoráková, L. The physicochemical and biological properties of zinc(II) complexes. J. Therm. Anal. Calorim. 2007, 88, 355–361. [Google Scholar] [CrossRef]
- Cuajungco, M.P.; Ramirez, M.S.; Tolmasky, M.E. Zinc: Multidimensional effects on living organisms. Biomedicines 2021, 9, 208. [Google Scholar] [CrossRef] [PubMed]
- Ye, Q.; Chen, W.; Huang, H.; Tang, Y.; Wang, W.; Meng, F.; Wang, H.; Zheng, Y. Iron and zinc ions, potent weapons against multidrug-resistant bacteria. Appl. Microbiol. Biotechnol. 2020, 104, 5213–5227. [Google Scholar] [CrossRef]
- Abendrot, M.; Kalinowska-Lis, U. Zinc-containing compounds for personal care applications. Int. J. Cosmet. Sci. 2018, 40, 319–327. [Google Scholar] [CrossRef] [Green Version]
- Sánchez-Lόpez, E.; Gomes, D.; Esteruelas, G.; Bonilla, L.; Lopez-Machado, A.L.; Galindo, R.; Cano, A.; Espina, M.; Ettcheto, M.; Camins, A.; et al. Metal-based nanoparticles as antimicrobial agents: An overview. Nanomaterials 2020, 10, 292. [Google Scholar] [CrossRef] [Green Version]
- Raghupathi, K.R.; Koodali, R.T.; Manna, A.C. Size-dependent bacterial growth inhibition and mechanism of antibacterial activity of zinc oxide nanoparticles. Langmuir 2011, 27, 4020–4028. [Google Scholar] [CrossRef]
- Liang, J.; Sun, D.; Yang, Y.; Li, M.; Li, H.; Chen, L. Discovery of metal-based complexes as promising antimicrobial agents. Eur. J. Med. Chem. 2021, 224, 113696. [Google Scholar] [CrossRef]
- Gupta, M.; Mahajan, V.K.; Mehta, K.S.; Chauhan, P.S. Zinc therapy in dermatology: A review. Dermatol. Res. Pract. 2014, 2014, 709152. [Google Scholar] [CrossRef] [PubMed]
- Pittol, M.; Tomachesk, D.; Simões, D.N.; Ribeiro, V.F.; Santana, R.M.C. Antimicrobial performance of thermoplastic elastomers containing zinc pyrithione and silver nanoparticles. Mater. Res. 2017, 20, 1266–1273. [Google Scholar] [CrossRef] [Green Version]
- Kalinowska, M.; Sienkiewicz-Gromiuk, J.; Świderski, G.; Pietryczuk, A.; Cudowski, A.; Lewandowski, W. Zn(II) complex of plant phenolic chlorogenic acid: Antioxidant, antimicrobial and structural studies. Materials 2020, 13, 3745. [Google Scholar] [CrossRef] [PubMed]
- Kalinowska, M.; Piekut, J.; Bruss, A.; Follet, C.; Sienkiewicz-Gromiuk, J.; Świsłocka, R.; Rzączyńska, Z.; Lewandowski, W. Spectroscopic (FT-IR, FT-Raman, 1H, 13C NMR, UV/VIS), thermogravimetric and antimicrobial studies of Ca(II), Mn(II), Cu(II), Zn(II) and Cd(II) complexes of ferulic acid. Spectrochim. Acta A Mol. Biomol. Spectrosc. 2014, 122, 631–638. [Google Scholar] [CrossRef] [PubMed]
- Andrejević, T.P.; Warżajtis, B.; Glišić, B.Đ.; Vojnovic, S.; Mojicevic, M.; Stevanović, N.L.; Nikodinovic-Runic, J.; Rychlewska, U.; Djuran, M.I. Zinc(II) complexes with aromatic nitrogen-containing heterocycles as antifungal agents: Synergistic activity with clinically used drug nystatin. J. Inorg. Biochem. 2020, 208, 111089. [Google Scholar] [CrossRef] [PubMed]
- McCall, K.A.; Huang, C.; Fierke, C.A. Zinc and SARS-CoV-2: A molecular modeling study of Zn interactions with RNA-dependent RNA-polymerase and 3C-like proteinase enzymes. Int. J. Mol. Med. 2021, 47, 326–334. [Google Scholar]
- Andrejević, T.P.; Milivojevic, D.; Glišić, B.Đ.; Kljun, J.; Stevanović, N.L.; Vojnovic, S.; Medic, S.; Nikodinovic-Runic, J.; Turel, I.; Djuran, M.I. Silver(I) complexes with different pyridine-4,5-dicarboxylate ligands as efficient agents for the control of cow mastitis associated pathogens. Dalton Trans. 2020, 49, 6084–6096. [Google Scholar] [CrossRef]
- Andrejević, T.P.; Aleksic, I.; Počkaj, M.; Kljun, J.; Milivojevic, D.; Stevanović, N.L.; Nikodinovic-Runic, J.; Turel, I.; Djuran, M.I.; Glišić, B.Đ. Tailoring copper(II) complexes with pyridine-4,5-dicarboxylate esters for anti-Candida activity. Dalton Trans. 2021, 50, 2627–2638. [Google Scholar] [CrossRef]
- Traven, K.; Eleftheriadis, N.; Seršen, S.; Kljun, J.; Bezenšek, J.; Stanovnik, B.; Turel, I.; Dekker, F.J. Ruthenium complexes as inhibitors of 15-lipoxygenase-1. Polyhedron 2015, 101, 306–313. [Google Scholar] [CrossRef]
- Traven, K.; Sinreih, M.; Stojan, J.; Seršen, S.; Kljun, J.; Bezenšek, J.; Stanovnik, B.; Turel, I.; Lanišnik Rižner, T. Ruthenium complexes as inhibitors of the aldo–keto reductases AKR1C1–1C3. Chem.-Biol. Interact. 2015, 234, 349–359. [Google Scholar] [CrossRef]
- Traven, K.; Turel, I.; Koziskova, J.; Bučinský, L.; Kozisek, J. Concomitant polymorphism in an organometallic ruthenium(II) complex with an N,N′-donor ligand. Acta Crystallogr. C Struct. Chem. 2018, 74, 683–689. [Google Scholar] [CrossRef] [PubMed]
- Yang, L.; Powella, D.R.; Houser, R.P. Structural variation in copper(I) complexes with pyridylmethylamide ligands: Structural analysis with a new four-coordinate geometry index, τ4. Dalton Trans. 2007, 955–964. [Google Scholar] [CrossRef]
- Okuniewski, A.; Rosiak, D.; Chojnacki, J.; Becker, B. Coordination polymers and molecular structures among complexes of mercury(II) halides with selected 1-benzoylthioureas. Polyhedron 2015, 90, 47–57. [Google Scholar] [CrossRef]
- Rosiak, D.; Okuniewski, A.; Chojnacki, J. Novel complexes possessing Hg–(Cl, Br, I)⋯O=C halogen bonding and unusual Hg2S2(Br/I)4 kernel. The usefulness of τ4′ structural parameter. Polyhedron 2018, 146, 35–41. [Google Scholar] [CrossRef]
- Geary, W.J. The use of conductivity measurements in organic solvents for the characterisation of coordination compounds. Coord. Chem. Rev. 1971, 7, 81–122. [Google Scholar] [CrossRef]
- Liu, H.; Köhler, J.; Fink, G.R. Suppression of hyphal formation in Candida albicans by mutation of a STE12 homolog. Science 1994, 266, 1723–1726. [Google Scholar] [CrossRef]
- Pierce, C.G.; Uppuluri, P.; Tristan, A.R.; Wormley, F.L., Jr.; Mowat, E.; Ramage, G.; Lopez-Ribot, J.L. A simple and reproducible 96-well plate-based method for the formation of fungal biofilms and its application to antifungal susceptibility testing. Nat. Protoc. 2008, 3, 1494–1500. [Google Scholar] [CrossRef]
- Stevanović, N.L.; Aleksic, I.; Kljun, J.; Bogojevic, S.S.; Veselinovic, A.; Nikodinovic-Runic, J.; Turel, I.; Djuran, M.I.; Glišić, B.Đ. Copper(II) and Zinc(II) complexes with the clinically used fluconazole: Comparison of antifungal activity and therapeutic potential. Pharmaceuticals 2021, 14, 24. [Google Scholar] [CrossRef]
- López-Ribot, J.L. Candida albicans biofilms: More than filamentation. Curr. Biol. 2005, 15, R453–R455. [Google Scholar] [CrossRef] [Green Version]
- Krzyżek, P. Challenges and limitations of anti-quorum sensing therapies. Front. Microbiol. 2019, 10, 2473. [Google Scholar] [CrossRef] [Green Version]
- Chen, X.; Zhang, L.; Zhang, M.; Liu, H.; Lu, P.; Lin, K. Quorum sensing inhibitors: A patent review (2014–2018). Expert Opin. Ther. Pat. 2018, 28, 849–865. [Google Scholar] [CrossRef] [PubMed]
- Stevanović, N.L.; Kljun, J.; Aleksic, I.; Bogojevic, S.S.; Milivojevic, D.; Veselinovic, A.; Turel, I.; Djuran, M.I.; Nikodinovic-Runic, J.; Glišić, B.Đ. Clinically used antifungal azoles as ligands for gold(III) complexes: The influence of the Au(III) ion on the antimicrobial activity of the complex. Dalton Trans. 2022, 51, 5322–5334. [Google Scholar] [CrossRef] [PubMed]
- Lakowicz, J.R. Principles of Fluorescence Spectroscopy, 3rd ed.; Plenum Press: New York, NY, USA, 2006. [Google Scholar]
- Smoleński, P.; Pettinari, C.; Marchetti, F.; da Silva, M.F.C.G.; Lupidi, G.; Patzmay, G.V.B.; Petrelli, D.; Vitali, L.A.; Pomberio, A.J.L. Syntheses, structures, and antimicrobial activity of new remarkably light-stable and water-soluble tris(pyrazolyl)methanesulfonate silver(I) derivatives of N-methyl-1,3,5-triaza-7-phosphaadamantane salt—[mPTA]BF4. Inorg. Chem. 2015, 54, 434–440. [Google Scholar] [CrossRef] [PubMed]
- Pavic, A.; Savić, N.D.; Glišić, B.Đ.; Crochet, A.; Vojnovic, S.; Kurutos, A.; Stanković, D.M.; Fromm, K.M.; Nikodinovic-Runic, J.; Djuran, M.I. Silver(I) complexes with 4,7-phenanthroline efficient in rescuing the zebrafish embryos of lethal Candida albicans infection. J. Inorg. Biochem. 2019, 195, 149–163. [Google Scholar] [CrossRef] [Green Version]
- Shi, Y.; Guo, C.; Sun, Y.; Liu, Z.; Xu, F.; Zhang, Y.; Wen, Z.; Li, Z. Interaction between DNA and microcystin-LR studied by spectra analysis and atomic force microscopy. Biomacromolecules 2011, 12, 797–803. [Google Scholar] [CrossRef] [PubMed]
- Pearson, R.G. Hard and soft acids and bases—The evolution of a chemical concept. Coord. Chem. Rev. 1990, 100, 403–425. [Google Scholar] [CrossRef]
- Wu, H.-L.; Li, W.-Y.; He, X.-W.; Miao, K.; Liang, H. Spectral studies of the binding of lucigenin, a bisacridinium derivative, with double-helix DNA. Anal. Bioanal. Chem. 2002, 373, 163–168. [Google Scholar] [CrossRef]
- Tarushi, A.; Totta, X.; Papadopoulos, A.; Kljun, J.; Turel, I.; Kessissoglou, D.P.; Psomas, G. Antioxidant activity and interaction with DNA and albumins of zinc–tolfenamato complexes. Crystal structure of [Zn(tolfenamato)2(2,2′-dipyridylketoneoxime)2]. Eur. J. Med. Chem. 2014, 74, 187–198. [Google Scholar] [CrossRef]
- Rajendiran, V.; Karthik, R.; Palaniandavar, M.; Stoeckli-Evans, H.; Periasamy, V.S.; Akbarsha, M.A.; Srinag, B.S.; Krishnamurthy, H. Mixed-ligand copper(II)-phenolate complexes: effect of coligand on enhanced DNA and protein binding, DNA cleavage, and anticancer activity. Inorg. Chem. 2007, 46, 8208–8221. [Google Scholar] [CrossRef]
- Li, D.; Zhu, M.; Xu, C.; Ji, B. Characterization of the baicalein–bovine serum albumin complex without or with Cu2+ or Fe3+ by spectroscopic approaches. Eur. J. Med. Chem. 2011, 46, 588–599. [Google Scholar] [CrossRef]
- Hemmateenejad, B.; Shamsipur, M.; Samari, F.; Khayamian, T.; Ebrahimi, M.; Rezaei, Z. Combined fluorescence spectroscopy and molecular modeling studies on the interaction between harmalol and human serum albumin. J. Pharm. Biomed. Anal. 2012, 67, 201–208. [Google Scholar] [CrossRef] [PubMed]
- Da Silva, J.G.; Recio Despaigne, A.A.; Louro, S.R.W.; Bandeira, C.C.; Souza-Fagundes, E.M.; Beraldo, H. Cytotoxic activity, albumin and DNA binding of new copper(II) complexes with chalcone-derived thiosemicarbazones. Eur. J. Med. Chem. 2013, 65, 415–426. [Google Scholar] [CrossRef] [PubMed]
- Bezenšek, J.; Prek, B.; Grošelj, U.; Kasunič, M.; Svete, J.; Stanovnik, B. A simple metal-free synthesis of 2-substituted pyridine-4,5-dicarboxylates and their N-oxides. Tetrahedron 2012, 68, 4719–4731. [Google Scholar] [CrossRef]
- Oxford Diffraction Ltd. CrysAlis PRO; Agilent Technologies: Yarnton, UK, 2011. [Google Scholar]
- Dolomanov, O.V.; Bourhis, L.J.; Gildea, R.J.; Howard, J.A.K.; Puschmann, H. OLEX2: A complete structure solution, refinement and analysis program. J. Appl. Crystallogr. 2009, 42, 339–341. [Google Scholar] [CrossRef]
- Sheldrick, G.M. Shelxl 2018/3; University of Göttingen: Göttingen, Germany, 2018. [Google Scholar]
- Macrae, C.F.; Edgington, P.R.; McCabe, P.; Pidcock, E.; Shields, G.P.; Taylor, R.; Towler, M.; van de Streek, J. Mercury: Visualization and analysis of crystal structures. J. Appl. Crystallogr. 2006, 49, 453–457. [Google Scholar] [CrossRef] [Green Version]
- Arendrup, M.C.; Cuenca-Estrella, M.; Lass-Flörl, C.; Hope, W. the EUCAST-AFST. EUCAST technical note on the EUCAST definitive document EDef 7.2: Method for the determination of broth dilution minimum inhibitory concentrations of antifungal agents for yeasts EDef 7.2 (EUCAST-AFST). Clin. Microbiol. Infect. 2012, 18, E246–E247. [Google Scholar] [CrossRef] [Green Version]
- McClean, K.H.; Winson, M.K.; Fish, L.; Taylor, A.; Chhabra, S.R.; Camara, M.; Daykin, M.; Lamb, J.H.; Swift, S.; Bycroft, B.W.; et al. Quorum sensing and Chromobacterium violaceum: Exploitation of violacein production and inhibition for the detection of N-acylhomoserine lactones. Microbiology 1997, 143, 3703–3711. [Google Scholar] [CrossRef] [Green Version]
- Aleksić, I.; Šegan, S.; Andrić, F.; Zlatović, M.; Moric, I.; Opsenica, D.M.; Senerovic, L. Long-chain 4-aminoquinolines as quorum sensing inhibitors in Serratia marcescens and Pseudomonas aeruginosa. ACS Chem. Biol. 2017, 12, 1425–1434. [Google Scholar] [CrossRef] [Green Version]
- Ferrer, F.; Fanciullino, R.; Milano, G.; Ciccolini, J. Towards rational cancer therapeutics: Optimizing dosing, delivery, scheduling, and combinations. Clin. Pharmacol. Ther. 2020, 108, 458–470. [Google Scholar] [CrossRef]
- Stiernagle, T. Maintenance of C. elegans; The C. elegans Research Community, Ed.; WormBook: Minneapolis, MN, USA, 2006. [Google Scholar]
- Brackman, G.; Cos, P.; Maes, L.; Nelis, H.J.; Coenye, T. Quorum sensing inhibitors increase the susceptibility of bacterial biofilms to antibiotics in vitro and in vivo. Antimicrob. Agents Chemother. 2011, 55, 2655–2661. [Google Scholar] [CrossRef] [Green Version]
- Wolfe, A.; Shimer, G.H., Jr.; Meehan, T. Polycyclic aromatic hydrocarbons physically intercalate into duplex regions of denatured DNA. Biochemistry 1987, 26, 6392–6396. [Google Scholar] [CrossRef] [PubMed]
- Savić, N.D.; Vojnovic, S.; Glišić, B.Đ.; Crochet, A.; Pavic, A.; Janjić, G.V.; Pekmezović, M.; Opsenica, I.M.; Fromm, K.M.; Nikodinovic-Runic, J.; et al. Mononuclear silver(I) complexes with 1,7-phenanthroline as potent inhibitors of Candida growth. Eur. J. Med. Chem. 2018, 156, 760–773. [Google Scholar] [CrossRef] [PubMed] [Green Version]

| Compound | 1 | 2 |
|---|---|---|
| Zn-N1; Å | 2.071(1) | 2.069(3) |
| a Zn-N1′; Å | 2.069(1) | 2.062(3) |
| Zn-X; Å | 2.2099(7), 2.2017(8) | 2.3369(9), 2.3399(7) |
| X-Zn-X; ° | 114.58(2) | 113.35(2) |
| b φ; ° | 81.15 | 80.02 |
| c τ4 [32] | 0.85 | 0.83 |
| c τ’4 [33,34] | 0.82 | 0.80 |
| Compound | 1 | 2 | ZnCl2 | ZnBr2 | py-2py | |
|---|---|---|---|---|---|---|
| Test Organism | ||||||
| Pseudomonas aeruginosa NCTC 10332 | >500 | >500 | >500 | >500 | >500 | |
| Staphylococcus aureus ATCC 25923 | 500 | >500 | 500 | 500 | >500 | |
| Candida albicans ATCC 10231 | 62.5 | >500 | >500 | >500 | >500 | |
| Candida parapsilosis ATCC 22019 | 62.5 | >500 | >500 | >500 | >500 | |
| MRC-5 cells | 33 ± 1 | 75 ± 2 | 36 ± 1 | 22 ± 1 | 120 ± 4 | |
| Complex | Ksv (M−1) | Hypochromism (%) | Kq (M−1 s−1) | KA (M−1) | n |
|---|---|---|---|---|---|
| 1 | (9.28 ± 0.01) × 102 | 14.8 | 9.28 × 1010 | 14.2 | 0.49 |
| 2 | (1.73 ± 0.01) × 103 | 14.4 | 1.73 × 1011 | 7.77 × 104 | 1.45 |
| Complex | Ksv (M−1) | Hypochromism (%) | Kq (M−1 s−1) | KA (M−1) | n |
|---|---|---|---|---|---|
| 1 | (5.33 ± 0.07) × 104 | 74.7 | 5.23 × 1012 | 2.20 × 105 | 1.19 |
| 2 | (1.78 ± 0.05) × 104 | 45.6 | 1.78 × 1012 | 3.17 × 104 | 1.07 |
| Complex | Ksv (M−1) | Hypochromism (%) | Kq (M−1 s−1) | KA (M−1) | n | |
|---|---|---|---|---|---|---|
| ∆λ = 15 nm | 1 | (1.07 ± 0.02) × 106 | 78.0 | 1.07 × 1014 | 4.82 × 106 | 1.52 |
| 2 | (3.23 ± 0.01) × 104 | 67.2 | 3.23 × 1012 | 2.90 × 105 | 1.30 | |
| ∆λ = 60 nm | 1 | (5.23 ± 0.01) × 104 | 70.2 | 5.23 × 1012 | 1.89 × 105 | 1.22 |
| 2 | (4.39 ± 0.01) × 104 | 70.1 | 4.39 × 1012 | 6.90 × 105 | 1.38 |
Publisher’s Note: MDPI stays neutral with regard to jurisdictional claims in published maps and institutional affiliations. |
© 2022 by the authors. Licensee MDPI, Basel, Switzerland. This article is an open access article distributed under the terms and conditions of the Creative Commons Attribution (CC BY) license (https://creativecommons.org/licenses/by/4.0/).
Share and Cite
Andrejević, T.P.; Aleksic, I.; Kljun, J.; Pantović, B.V.; Milivojevic, D.; Vojnovic, S.; Turel, I.; Djuran, M.I.; Glišić, B.Đ. Zinc(II) Complexes with Dimethyl 2,2′-Bipyridine-4,5-dicarboxylate: Structure, Antimicrobial Activity and DNA/BSA Binding Study. Inorganics 2022, 10, 71. https://doi.org/10.3390/inorganics10060071
Andrejević TP, Aleksic I, Kljun J, Pantović BV, Milivojevic D, Vojnovic S, Turel I, Djuran MI, Glišić BĐ. Zinc(II) Complexes with Dimethyl 2,2′-Bipyridine-4,5-dicarboxylate: Structure, Antimicrobial Activity and DNA/BSA Binding Study. Inorganics. 2022; 10(6):71. https://doi.org/10.3390/inorganics10060071
Chicago/Turabian StyleAndrejević, Tina P., Ivana Aleksic, Jakob Kljun, Bojana V. Pantović, Dusan Milivojevic, Sandra Vojnovic, Iztok Turel, Miloš I. Djuran, and Biljana Đ. Glišić. 2022. "Zinc(II) Complexes with Dimethyl 2,2′-Bipyridine-4,5-dicarboxylate: Structure, Antimicrobial Activity and DNA/BSA Binding Study" Inorganics 10, no. 6: 71. https://doi.org/10.3390/inorganics10060071
APA StyleAndrejević, T. P., Aleksic, I., Kljun, J., Pantović, B. V., Milivojevic, D., Vojnovic, S., Turel, I., Djuran, M. I., & Glišić, B. Đ. (2022). Zinc(II) Complexes with Dimethyl 2,2′-Bipyridine-4,5-dicarboxylate: Structure, Antimicrobial Activity and DNA/BSA Binding Study. Inorganics, 10(6), 71. https://doi.org/10.3390/inorganics10060071

